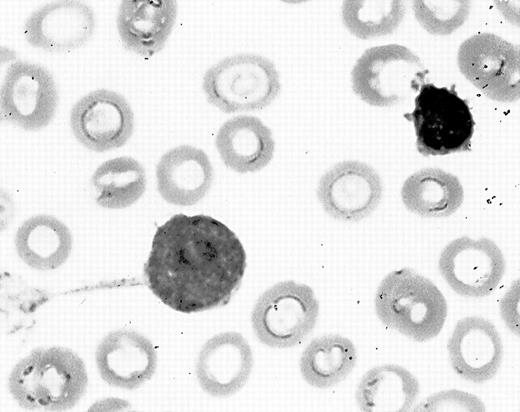
Fig. 1. Blast-forming tenupods in bone marrow aspirate smear of a patient with acute monoblastic leukemia.

To the Editor:
Primitive hematopoietic myeloid cells have been observed to extend long, thin pseudopodia. Recently, Francis et al1 reported the presence of 2 new morphologic types of pseudopodia, tenupodia and magnupodia, formed by the human myeloid progenitor cell line KG1a and human CD34+ cells from fetal liver, umbilical cord blood, adult bone marrow, and mobilized (using either granulocyte-macrophage colony-stimulating factor [GM-CSF] or G-CSF) peripheral blood. Tenupodia are thin, linear segments that bifurcate multiple times. Magnupodia are thicker, longer, flexible dynamic segments that both extend and retract. Francis et al1 suggested that tenupods and magnupods play both sensory and mechanical roles during migration and homing of hematopoietic stem cells.
The human CD34+ cells displaying tenupods and magnupods reported by Francis et al1 were isolated after several purification steps including immunomagnetic separation column, flow cytometric sorting, cell culture, and cryopreservation. Francis et al1 did not assess for the presence of tenupodia and magnupodia formation by blasts in bone marrow aspirate smears from patients with acute myeloid leukemia. This case is reported to illustrate blasts forming tenupods in bone marrow aspirate smears of a patient with acute monoblastic leukemia.
A 7-month-old Hispanic girl was admitted to M.D. Anderson Cancer Center on November 22, 1998 with a 2-week history of erythematous sclera followed by proptosis of the right eye. The previous medical history was unremarkable. Her developmental milestones were within normal limits. Physical examination revealed temperature 36.4°F, pulse 126 beats/min, respiratory rate 26 breaths/min, blood pressure 119/71 mm Hg, weight 8.5 kg, and height 43 cm. The right eye showed mild proptosis and a dilated pupil, unresponsive to light. Fundoscopy exam demonstrated a yellow retina. The left eye was normal. There were no skin lesions or visceromegaly. Complete blood count (CBC) revealed hemoglobin 6.4 g/dL, platelet count 14,000/μL, and white blood cell count 5,500/μL. The peripheral blood smear differential count was: 11% neutrophils, 84% lymphocytes, 3% monocytes, 1% eosinophils, and 1% basophils. The serum lactate dehydrogenase (LDH) was 1,222 U/L (normal, 118 to 273 U/L). She required transfusions of platelets and red blood cells. Computed tomographic (CT) scan showed diffuse opacification of the retrobulbar tissue with no bone destruction. Biopsy specimens of the retrobulbar tissue showed mature adipose tissue and fibrosis with no evidence of malignancy. Bone marrow aspiration was done on November 26, 1998 and smears showed 11% blasts, orderly granulopoiesis and erythropoiesis, and megakaryocytic hypoplasia. The blasts extended long, thin pseudopodia that originated from a common site on the cell surface with branches at some distance away from the cell body (Fig 1). Cytochemical studies showed that the blasts were negative for myeloperoxidase, terminal deoxynucleotidyl transferase (TdT), Periodic Acid-Schiff (PAS) reaction, and butyrate esterase. Flow cytometry immunophenotypic studies showed that the blasts were positive for CD33, CD34, CD45, and CD117 demonstrating immature myeloid lineage. Cytogenetic study showed a normal 46, XX karyotype.
Blast-forming tenupods in bone marrow aspirate smear of a patient with acute monoblastic leukemia.
Blast-forming tenupods in bone marrow aspirate smear of a patient with acute monoblastic leukemia.
Subsequently, bone marrow aspiration and biopsy were performed on December 20, 1998. The aspiration yielded a dry tap, but bone marrow biopsy touch imprints demonstrated 98% blasts. The bone marrow biopsy specimen was hypercellular, greater than 90%, and the architecture was effaced by large infiltrating cells with distinct nucleoli. Cytochemical studies showed that the blasts were positive for butyrate esterase and negative for myeloperoxidase and TdT. Immunohistochemical studies performed using fixed, paraffin-embedded tissue sections showed that the neoplastic cells strongly expressed CD45 and CD68. In aggregate, these findings established the diagnosis of acute monoblastic leukemia (M5 using the French-American-British classification).2
We observed blasts deploying tenupodia in the bone marrow aspirate smears in the early phase of this patient’s acute myeloid leukemia. The lack of adequate bone marrow aspiration smears may explain our inability to identify these tenupodia later in the patient’s clinical course, when the acute leukemia was florid. Tenupodia formation by leukemic monoblasts in the bone marrow suggests that tenupodia are somehow involved in replacement of the bone marrow space. These tenupodia may be involved in the interaction between blasts and the bone marrow microenvironment, which probably also involves adhesion molecules such as fibronectin, integrin α5β1, vinculin, and actin.3 Tenupodia may play a role in cell-to-cell interaction. According to Francis et al,1 tenupods adhere to substrate and can bifurcate multiple times to connect to the membranes of cells up to 330 μmol/L apart. Tenupodia may also be involved in migration, as migration requires the cell to deform, extending cytoplasmic projections and generating contractile forces as it moves.
Response
To the Editor:
This recent report by Bueso-Ramos1-1 describes the presence of tenupodia in bone marrow aspirate smears. Our original description of tenupodia focused on CD34+ cells and the CD34+ cell line KG1a.1-2 The observation of extension of tenupodia by blast cells reported by Bueso-Ramos et al are in agreement with our findings, and provide an independent verification of tenupodia extension by hematopoietic cells.
We have now observed these podia in mixed cell cultures and our research has shown that other cell phenotypes extend tenupodia. In Fig1-1, primitive hematopoietic KG1a cells (red—PKH26 stained) were cocultured with fibroblastic HT1080 cells (green—PKH2 stained) to simulate the heterogeneous cellularity of the bone marrow microenvironment. We found that the KG1a cells form connections with the HT1080 cells via red tenupodia (shown in Fig 1-1). Additionally, tenupodia that originated from the HT1080 cells and connected with the KG1a cells appeared green (not shown). These observations provide evidence that suggests tenupodia are involved in heterogeneous inter-cellular interactions.
CD34+ KG1a cell with tenupodia that contact fibroblastic HT1080 cells.
Although we have yet to elucidate the function of these tenupodia mediated inter-cellular interactions, we are continuing to investigate other aspects of tenupodia and magnupodia formation. Using immunohistochemical staining, we have cataloged the various surface markers and adhesion molecules that appear on these podia.1-3We have also succeeded in transiently transfecting KG1a cells with an actin-green fluorescent protein construct. Confocal images of these cells revealed that actin is indeed present in magnupodia. These studies show that the podia contain molecular components that one would expect to find in and on the surface of these podia. However, their in vivo physiological role remains uncertain. The podia can possibly play a role in navigation and migration, long distance cell-cell interaction, or even in controlled cell death processes. Further investigation is required to determine their physiological function.

This feature is available to Subscribers Only
Sign In or Create an Account Close Modal